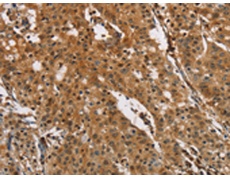
一抗

中文名稱: 兔抗PTK6多克隆抗體
英文名稱: Anti-PTK6 rabbit polyclonal antibody
別 名: BRK
相關(guān)類別: 一抗
抗 原: PTK6
儲 存: 冷凍(-20℃)
宿 主: Rabbit
反應(yīng)種屬: Human, Mouse
標(biāo) 記 物: Unconjugate
克隆類型: rabbit polyclonal
技術(shù)規(guī)格
|
Background: |
The protein encoded by this gene is a cytoplasmic nonreceptor protein kinase which may function as an intracellular signal transducer in epithelial tissues. Overexpression of this gene in mammary epithelial cells leads to sensitization of the cells to epidermal growth factor and results in a partially transformed phenotype. Expression of this gene has been detected at low levels in some breast tumors but not in normal breast tissue. The encoded protein has been shown to undergo autophosphorylation. Alternative splicing results in multiple transcript variants. |
|
Applications: |
ELISA, IHC |
|
Name of antibody: |
PTK6 |
|
Immunogen: |
Fusion protein of human PTK6 |
|
Full name: |
protein tyrosine kinase 6 |
|
Synonyms: |
BRK |
|
SwissProt: |
Q13882 |
|
IHC positive control: |
Human gastric cancer |
|
IHC Recommend dilution: |
50-200 |

 購物車
購物車 幫助
幫助
 021-54845833/15800441009
021-54845833/15800441009